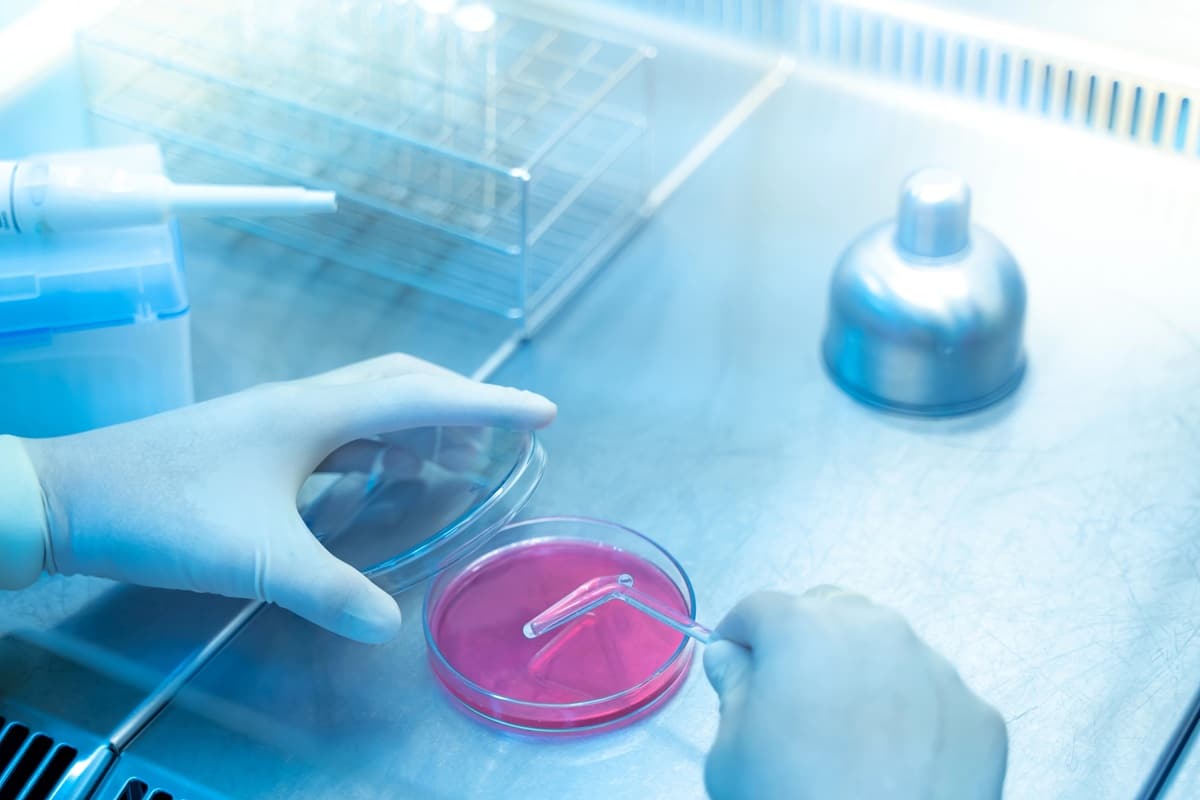

Un reciente informe de la Organización Mundial de la Salud (OMS) revela que la resistencia a los antibióticos está aumentando a un ritmo alarmante, superando los avances en el campo médico. Según el estudio, entre 2018 y 2023, más del 40% de las combinaciones de patógeno-antibiótico monitoreadas mostraron un incremento en la resistencia, con un aumento anual que varía entre el 5% y el 15%.
El informe, que incluye datos recabados de más de 100 países a través del Sistema Mundial de Vigilancia de la Resistencia a los Antimicrobianos (GLASS), indica que una de cada seis infecciones bacterianas confirmadas en laboratorio resultó ser resistente a los tratamientos antibióticos. Esto representa una advertencia seria sobre cómo la resistencia a los antibióticos podría amenazar la salud pública a nivel global.
Por primera vez, la OMS ha proporcionado estimaciones sobre la resistencia en 22 antibióticos utilizados para tratar infecciones urinarias, gastrointestinales, en el torrente sanguíneo y la gonorrea, abarcando ocho patógenos bacterianos comunes: Acinetobacter spp., Escherichia coli, Klebsiella pneumoniae, Neisseria gonorrhoeae, Salmonella spp. no tifoidea, Shigella spp., Staphylococcus aureus y Streptococcus pneumoniae.
La región de Asia Sudoriental y la del Mediterráneo Oriental son las que presentan el mayor nivel de resistencia, con una de cada tres infecciones notificadas siendo resistentes. En el continente africano, la cifra es de una de cada cinco infecciones. Se destaca que la resistencia tiende a ser más prevalente en áreas donde los sistemas de salud no cuentan con la capacidad necesaria para diagnosticar o tratar adecuadamente estas infecciones.
El Dr. Tedros Adhanom Ghebreyesus, Director General de la OMS, enfatizó que “la resistencia a los antimicrobianos va más rápida que los avances en la medicina moderna, lo que constituye una amenaza para la salud de las familias en todo el mundo”. Hizo un llamado a los países para que fortalezcan sus sistemas de vigilancia y utilicen los antibióticos de manera responsable, garantizando al mismo tiempo el acceso a medicamentos, diagnósticos de calidad y vacunas adecuadas.
El informe también destaca que las bacterias gramnegativas resistentes son un reto creciente, particularmente en naciones con recursos limitados. Las infecciones por E. coli y K. pneumoniae son las más comunes en infecciones sanguíneas, con más del 40% de los casos de E. coli y 55% de K. pneumoniae mostrando resistencia a las cefalosporinas de tercera generación, consideradas el tratamiento estándar. En África, la resistencia a estas cepas incluso supera el 70%.
La situación se complica aún más, ya que otros antibióticos vitales, como los carbapenémicos y las fluoroquinolonas, están mostrando una disminución en su efectividad. La resistencia a los carbapenémicos, que anteriormente era inusual, se está volviendo más común, lo que limita las opciones de tratamiento y obliga a utilizar antibióticos de último recurso, que suelen ser costosos y difíciles de conseguir, especialmente en países de ingresos bajos y medianos.
Desde 2016, el número de países que participan en el GLASS se ha cuadruplicado, pasando de 25 a 104 en 2023. Sin embargo, el 48% de los países no reportaron datos al GLASS este año y muchos aún carecen de sistemas que generen información confiable. La falta de capacidad de vigilancia es especialmente crítica en las naciones que enfrentan mayores desafíos en esta área.
En la reciente declaración política sobre la resistencia a los antimicrobianos adoptada en la Asamblea General de las Naciones Unidas en 2024, se establecieron metas para abordar este problema mediante el fortalecimiento de los sistemas de salud y la implementación de un enfoque de “Una sola salud”, que incluye la coordinación entre los sectores de salud humana, animal y medioambiental.
Para hacer frente al creciente desafío de la resistencia a los antimicrobianos, es esencial que los países se comprometan a mejorar sus sistemas de laboratorio y a generar datos de vigilancia confiables, especialmente en áreas desatendidas, con el fin de guiar tratamientos y políticas efectivas.
La OMS hace un llamado a todas las naciones para que envíen datos de calidad sobre la resistencia y el uso de antimicrobianos al GLASS antes de 2030, un objetivo que requerirá esfuerzos coordinados para mejorar la calidad y la cobertura geográfica de la vigilancia.
El informe se acompaña de contenido digital adicional que está disponible en el tablero GLASS de la OMS, el cual proporciona resúmenes globales y regionales, perfiles de países basados en la cobertura de vigilancia y datos sobre la resistencia, además de información detallada sobre el uso de antimicrobianos.